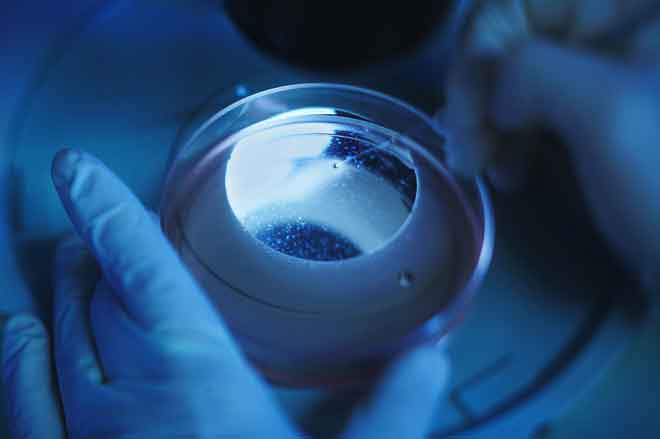

科学家成功地利用皮肤细胞生出老鼠! 人类也行只是目前太具争议性

1. 来自日本的研究小组把老鼠尾巴的皮肤细胞转换成生殖细胞,然后它们被用来做成能生育的老鼠胚胎。
2. 虽然这项研究在理论上能够转移到人类,但这类的实验是非常有争议的。因此,在人类身上的研究,将不会很快地发生。
一种新的诞生方法
不需要父母就能生出小孩,这是科幻小说的题材。但一项最近在自然期刊(Nature)被讨论的研究,来自日本九州大学(Kyushu University)的科学家可能很接近这个不可能的现象,因为他们已经成功地从老鼠皮肤细胞生出老鼠宝宝。
这项突破是由生殖生物学家Katsuhiko Hayashi所领导。老鼠的尾巴皮肤细胞首先被转换成干细胞,然后经过处理变成生殖细胞。母老鼠细胞被转换成卵子,而公老鼠细胞则转换成精子。从尾巴皮肤细胞到生殖细胞,是利用Hayashi和诺贝尔奖得主Shinya Yamanaka所发展的技术。
人工制造的卵子被放在含有老鼠卵巢细胞的培养皿,来模拟典型的受精环境。这样的安排是成功的,而且形成受精的胚胎。一些在试管内受精的胚胎在几星期后,生下26只老鼠宝宝。

Hayashi报告在他的实验室里的不同组重复这个过程,但程序是很有挑战性的。为了促进人工生殖科技,他说研究应该要找出一个方法,来省略从实际卵巢细胞创造出像卵巢环境的需要。
从老鼠到人类?
Hayashi很有信心他的小组发现为其他哺乳动物、甚至是人类,创造出一个充满机会的平台。关于卵子的品质,他的确在担心。在他的研究里,只有3.5%的人工胚胎成长为老鼠宝宝,远低于在老鼠卵巢内发展的卵子的60%成功率。

在一场与下一个大未来(Next Big Future)的访问中,基于Hayashi的研究,以色列魏茨曼科学研究所(Weizmann Institute of Science)的干细胞生物学家Jacob Hanna暗示着对于同性夫妇一个未来的可能性。理论上,皮肤细胞能够被转换成生殖细胞,同性夫妇或许可以变成生物学上的父母。然而,Hayashi还没有做实验,把公老鼠皮肤细胞转换成卵子。
复制人与人工繁殖是非常有争议的议题,尽管来自于皮肤的细胞生长在医学界是很有前途的,像是这种方法在心脏的再生细胞,许多人依然有这类实验在道德上的担心,以及我们如何来控制它。还不是很清楚像这样的方法将会多快出现在我们人类,但我们都正在等待着去找出来。

发表你的评论吧返回顶部
!评论内容需包含中文
